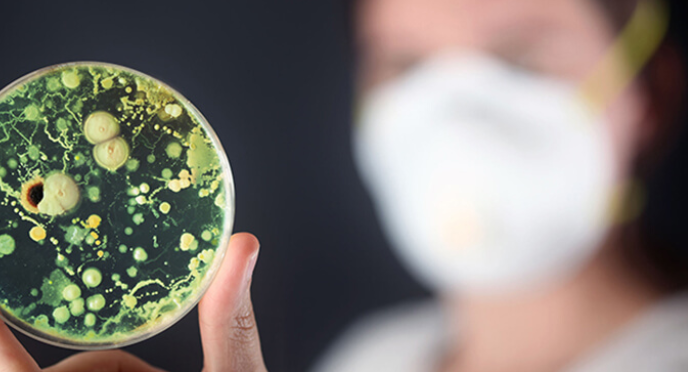
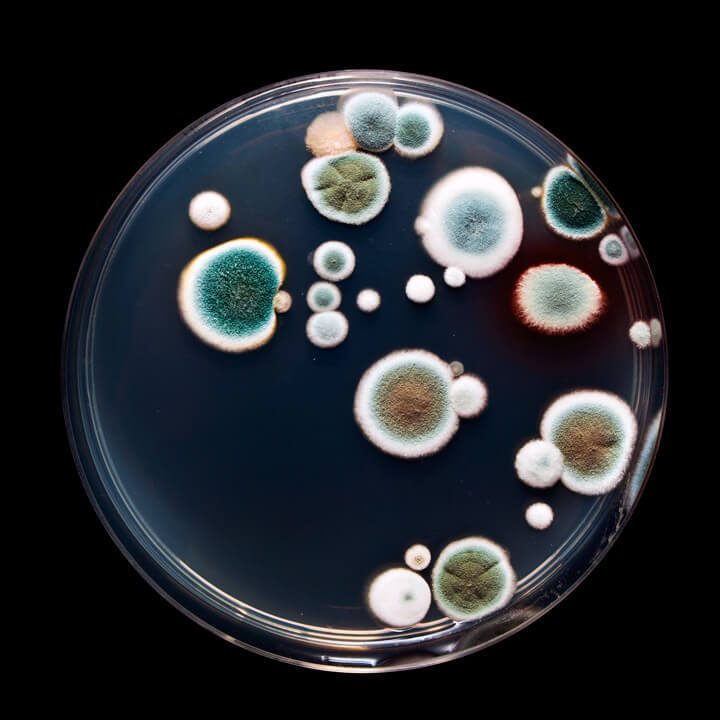

Признаки того, что в теле процветает плесень
Если грибок попал в организм человека, то избавление от него – серьёзная и масштабная задача. В наших силах способствовать укреплению тела и поддержке его в задаче сохранения здоровья.

Уже давно ни для кого не секрет, что тело человека очень сильно подвержено влиянию извне. Общую интоксикацию организма от неправильного питания и стрессов усиливают продукты жизнедеятельности паразитов и грибков. Многие недооценивают вред, который грибы наносят организму человека. Например, самый распространенный грибок, который поражает ногтевую пластину, некоторыми воспринимается всего лишь как внешний косметический дефект! Но это далеко не так! К сожалению, мицелий (тело грибов) часто распространяется по всему организму, вплоть до кровеносной и лимфатической системы, и может достигать даже самого мозга.
Какие-то грибки поражают лимфатические узлы в паху, другие под грудью, третьи поражают ногтевую пластину и живут только на ногтях.
Какие-то поражают только слизистые оболочки и живут во рту, в виде кандидозов и стоматитов, или во влагалище в виде кандидозов и вагинитов.
Какие-то грибки поражают кожные покровы и живут на коже в виде трещин, псориаза, экземы, нейродермита…
Внедряясь во внутреннее пространство человеческого организма, патогенные грибы вызывают заболевания, которые называются микозами (mycosis – гриб). Из них можно выделить наиболее распространенные:
микозы кожи (пестрый лишай, псориаз);
микозы ногтей (дерматомикозы);
микозы волосистых участков головы (пьедра, перхоть);
микозы внутренних органов (кандидоз, так называемая молочница).
Наш организм обладает хорошим защитным механизмом от заражения через пищевые продукты. Реализуется он через желудочный сок. По идее, концентрации желудочного сока в здоровом теле достаточно, чтобы не допустить проникновения плесневых грибов в желудочно-кишечный тракт. Но, к сожалению, состояние желудочно-кишечного тракта современного человека далеко не идеально…
Отдельно нужно выделить грибок Candida. В норме он живёт в толстой кишке каждого человека и участвует в различных внутренних процессах: в частности, уничтожает остатки непереваренных питательных веществ и выводит токсины в результате метаболических процессов. Кроме того, он заставляет иммунную систему всё время быть начеку, то есть способствует поддержанию естественной защиты организма. Но положительную роль этот грибок играет лишь до тех пор, пока в кишечнике сохраняется здоровый баланс микрофлоры. Если же он нарушается, этот грибок распространяется в организме чрезмерно, начинает выделять токсины, вызывающие различные болезни.
Отчего же нарушается баланс в кишечнике человека? Основной фактор — это неправильное питание, то есть отсутствие достаточного количества клетчатки и витаминов группы В; а также обилие сахара, являющегося питательной средой для дрожжей, различных углеводов: хлеба, макарон, йогуртов с добавками, сладких безалкогольных и алкогольных напитков, кондитерских изделий.
Также причиной нарушения баланса в кишечнике является хронический стресс и вырабатываемые в связи с ним гормоны. Так, например, кортизол повышает уровень сахара в крови, который, в свою очередь, способствует распространению грибка.
Плесень может вторгаться в организм и через кожу. Для этого, конечно, необходимы определенные условия: особенно упрощает дело высокая влажность, жаркая температура, а также наличие органических остатков (грязи или жира), которые служат пищей для плесени. И, конечно, необходим непосредственный контакт с источником заражения.

Особенно легко заразиться грибковой инфекцией через контакт с больным человеком, через обувь и предметы личной гигиены, в общественных банях, саунах, при микротравмах кожного покрова различных частей тела. Микротравмы – царапинки, опрелости, повреждения кожного покрова – нарушают естественную защитную функцию кожи, позволяя грибку проникнуть внутрь организма и поселиться в нем.
Также грибок может передаваться от матери к плоду через околоплодную жидкость. Ребёнок, заразившийся таким образом, может родиться, например, с аллергией или кандидозом. Поэтому будущей маме особенно важно проводить противогрибковые мероприятия, чтобы не допустить этого.
Распространенной причиной размножения грибка в организме является антибактериальная терапия: антибиотики не только разрушают болезнетворные бактерии, но и ускоряют развитие грибка. Риск грибкового заражения повышается и с возрастом, а также при ослабленном иммунитете.
стероиды (преднизолон, кортизон);
заместительная гормональная терапия;
химио- и лучевая терапия;
стимуляторы (алкоголь, сигареты);
отравления тяжелыми металлами;
некоторые диагностические процедуры и почечный диализ.
Признаки наличия грибков в организме человека
2. Трещины, пузыри и потертости – причём не просто мозоли от физического воздействия, а именно потертости непонятного происхождения. Везде, где шелушится, трескается и мокнет одновременно – есть вероятность наличия грибкового поражения.
3. Выделения – белые, творожистые – это тоже грибы. Такие выделения могут быть во влагалище, или из бронхов, миндалин, на языке. Налёта на языке быть не должно – язык должен быть розовым, с выраженными сосочками.
4. Участки с пониженной чувствительностью. Паразитируя в организме, грибок повреждает нервные окончания, не давая человеку испытывать боль. Так, в частности, к коже идёт огромное количество нервных окончаний, и если бы не этот механизм, то кожный покров, поражённый псориазом, постоянно бы раздражался и был чрезвычайно болезненным.
Первое, что нужно сделать – это прекратить дополнительное поступление грибков в организм, перестать употреблять дрожжевой хлеб, сыры, сладости, мучные изделия и другие продукты, способные быть источником заражения. Всё, что является дрожжевым, для нас несет определенную плесневую опасность. При этом дрожжи очень живучи, и выдерживают как очень низкую, так и очень высокую температуру. Так, если бросить пережаренные сухари в квас, он начнёт бурлить, пойдёт реакция с участием дрожжей…
Таким образом, если мы хотим, чтобы наш организм был свободен от грибов, мы должны перестать давать ему пищу.
Второе – это ослабить грибок с помощью специальных продуктов. Так, большинство противопаразитарных средств одновременно являются и противогрибковыми. Особенно можно выделить следующие продукты:
Все виды перца, редька, хрен, лук, чеснок (чеснок – абсолютно поразительный продукт, который является лучшим в борьбе с вирусами и бактериями, паразитами, кроме того, он также способствует выведению тяжелых металлов).
Все приправы: имбирь, зира, куркума, корица, лист лавровый, кориандр, мускатный орех и др.Все кислые ягоды: смородина, крыжовник, калина, рябина, брусника, клюква, облепиха, черника, ежевика, голубика.
Живица. Живица представляет собой клейкую густую массу, которая выделяется из надрезов или трещин на коре хвойных деревьев (кедра, сосны, пихты, ели). Это вещество, вытекая, постепенно застывает и превращается в смолу. В состав живицы входят фитонциды, эфирные масла и смоляные кислоты, которые и способны противостоять грибку.
Масло кедрового ореха, кунжутное, льняное масло. Ударный подход в период противомикозных мер – это приём по 1 чайной ложке масла за полчаса до еды, 3 раза в день. А если масло принимается просто для профилактики, то можно и один раз в сутки, но в течение более длительного периода. Кроме того, для профилактики можно добавлять в салат 1 чайную ложку такого масла.Прополис. Можно пить настойку прополиса, класть прополис в мёд или просто жевать его, держать во рту.
Гвоздика (специя). Её перемалывают в порошок на кофемолке (не следует покупать уже перемолотую гвоздику) и принимают по чайной ложке с верхом 2-3 раза в день, запивая теплой водой, натощак (не менее, чем за 30 минут до еды). Курс – 2 недели.
Масло чайного дерева. Если присутствует сильное грибковое поражение, можно принимать по одной капле этого масла, растворённого в любом жире, порядка двух месяцев.
Кисломолочный напиток курунга. Кефир может быть получен как под воздействием грибка, так и с помощью ацидофильных молочно-кислых бактерий. Такой кефир является лечебным. Если, например, взять 10 таблеток курунги и положите их в литр натурального молока, то получится прекрасный продукт с противогрибковым действием, потому что молочно-кислые бактерии способны восстановить баланс микрофлоры кишечника и уменьшить популяцию грибов.
Включить щелочные процедуры. Последовательный щелочной уход за телом с общими ваннами и регулярными ножными ванночками, регулярное использование «щелочных носков» очень сильно воздействуют на все патогенные организмы в теле человека.
Также при микозах важно щелочное питье и ежедневное употребление до 1,5 литров воды.
Важно не зацикливаться на борьбе с конкретными симптомами проявления грибов, а подходить к этому вопросу целостно. А это значит прежде всего понимать, что без изменение общей среды в организме, ситуацию не изменить.
Если мы посмотрим внутрь себя, то увидим и поймём, что внутренние способности нашего организма очень велики. В наших силах способствовать укреплению тела и поддержке его в задаче сохранения здоровья. Для этого нужны наша энергия, целеустремленность, знания, нужна большая вера, правильный образ жизни, который мы будем вести каждый день.
Уже давно ни для кого не секрет, что тело человека очень сильно подвержено влиянию извне. Общую интоксикацию организма от неправильного питания и стрессов усиливают продукты жизнедеятельности паразитов и грибков. Многие недооценивают вред, который грибы наносят организму человека. Например, самый распространенный грибок, который поражает ногтевую пластину, некоторыми воспринимается всего лишь как внешний косметический дефект! Но это далеко не так! К сожалению, мицелий (тело грибов) часто распространяется по всему организму, вплоть до кровеносной и лимфатической системы, и может достигать даже самого мозга.
Каждый грибок грибку рознь
Плесень – это слово объединяющее, на самом деле каждый грибок грибку рознь.Какие-то грибки поражают лимфатические узлы в паху, другие под грудью, третьи поражают ногтевую пластину и живут только на ногтях.
Какие-то поражают только слизистые оболочки и живут во рту, в виде кандидозов и стоматитов, или во влагалище в виде кандидозов и вагинитов.
Какие-то грибки поражают кожные покровы и живут на коже в виде трещин, псориаза, экземы, нейродермита…
Внедряясь во внутреннее пространство человеческого организма, патогенные грибы вызывают заболевания, которые называются микозами (mycosis – гриб). Из них можно выделить наиболее распространенные:
микозы кожи (пестрый лишай, псориаз);
микозы ногтей (дерматомикозы);
микозы волосистых участков головы (пьедра, перхоть);
микозы внутренних органов (кандидоз, так называемая молочница).
Как грибы попадают в организм?
Среди основных источников заражения, через которые грибок может попасть в организм человека, можно выделить испорченную пищу, несвежую воду. Так, если на каком-либо фрукте есть плесень – есть его уже нельзя! И даже если на одном из фруктов, лежащих вместе, есть плесень – риск того, что и на всех остальных она есть, очень велик.Наш организм обладает хорошим защитным механизмом от заражения через пищевые продукты. Реализуется он через желудочный сок. По идее, концентрации желудочного сока в здоровом теле достаточно, чтобы не допустить проникновения плесневых грибов в желудочно-кишечный тракт. Но, к сожалению, состояние желудочно-кишечного тракта современного человека далеко не идеально…
Отдельно нужно выделить грибок Candida. В норме он живёт в толстой кишке каждого человека и участвует в различных внутренних процессах: в частности, уничтожает остатки непереваренных питательных веществ и выводит токсины в результате метаболических процессов. Кроме того, он заставляет иммунную систему всё время быть начеку, то есть способствует поддержанию естественной защиты организма. Но положительную роль этот грибок играет лишь до тех пор, пока в кишечнике сохраняется здоровый баланс микрофлоры. Если же он нарушается, этот грибок распространяется в организме чрезмерно, начинает выделять токсины, вызывающие различные болезни.
Отчего же нарушается баланс в кишечнике человека? Основной фактор — это неправильное питание, то есть отсутствие достаточного количества клетчатки и витаминов группы В; а также обилие сахара, являющегося питательной средой для дрожжей, различных углеводов: хлеба, макарон, йогуртов с добавками, сладких безалкогольных и алкогольных напитков, кондитерских изделий.
Также причиной нарушения баланса в кишечнике является хронический стресс и вырабатываемые в связи с ним гормоны. Так, например, кортизол повышает уровень сахара в крови, который, в свою очередь, способствует распространению грибка.
Плесень может вторгаться в организм и через кожу. Для этого, конечно, необходимы определенные условия: особенно упрощает дело высокая влажность, жаркая температура, а также наличие органических остатков (грязи или жира), которые служат пищей для плесени. И, конечно, необходим непосредственный контакт с источником заражения.
Особенно легко заразиться грибковой инфекцией через контакт с больным человеком, через обувь и предметы личной гигиены, в общественных банях, саунах, при микротравмах кожного покрова различных частей тела. Микротравмы – царапинки, опрелости, повреждения кожного покрова – нарушают естественную защитную функцию кожи, позволяя грибку проникнуть внутрь организма и поселиться в нем.
Также грибок может передаваться от матери к плоду через околоплодную жидкость. Ребёнок, заразившийся таким образом, может родиться, например, с аллергией или кандидозом. Поэтому будущей маме особенно важно проводить противогрибковые мероприятия, чтобы не допустить этого.
Распространенной причиной размножения грибка в организме является антибактериальная терапия: антибиотики не только разрушают болезнетворные бактерии, но и ускоряют развитие грибка. Риск грибкового заражения повышается и с возрастом, а также при ослабленном иммунитете.

Другие факторы, благоприятствующие размножению грибков:
противозачаточные таблетки;стероиды (преднизолон, кортизон);
заместительная гормональная терапия;
химио- и лучевая терапия;
стимуляторы (алкоголь, сигареты);
отравления тяжелыми металлами;
некоторые диагностические процедуры и почечный диализ.
Признаки наличия грибков в организме человека
Какие же признаки могут указывать на наличие грибка в организме?
1. Наличие зуда: в первую очередь внешних покровов, но и, например, зуд внутреннего уха…2. Трещины, пузыри и потертости – причём не просто мозоли от физического воздействия, а именно потертости непонятного происхождения. Везде, где шелушится, трескается и мокнет одновременно – есть вероятность наличия грибкового поражения.
3. Выделения – белые, творожистые – это тоже грибы. Такие выделения могут быть во влагалище, или из бронхов, миндалин, на языке. Налёта на языке быть не должно – язык должен быть розовым, с выраженными сосочками.
4. Участки с пониженной чувствительностью. Паразитируя в организме, грибок повреждает нервные окончания, не давая человеку испытывать боль. Так, в частности, к коже идёт огромное количество нервных окончаний, и если бы не этот механизм, то кожный покров, поражённый псориазом, постоянно бы раздражался и был чрезвычайно болезненным.
Что делать при грибковом поражении?
Если грибок попал в организм человека, то избавление от него – серьёзная и масштабная задача.Первое, что нужно сделать – это прекратить дополнительное поступление грибков в организм, перестать употреблять дрожжевой хлеб, сыры, сладости, мучные изделия и другие продукты, способные быть источником заражения. Всё, что является дрожжевым, для нас несет определенную плесневую опасность. При этом дрожжи очень живучи, и выдерживают как очень низкую, так и очень высокую температуру. Так, если бросить пережаренные сухари в квас, он начнёт бурлить, пойдёт реакция с участием дрожжей…
Таким образом, если мы хотим, чтобы наш организм был свободен от грибов, мы должны перестать давать ему пищу.
Второе – это ослабить грибок с помощью специальных продуктов. Так, большинство противопаразитарных средств одновременно являются и противогрибковыми. Особенно можно выделить следующие продукты:
Все виды перца, редька, хрен, лук, чеснок (чеснок – абсолютно поразительный продукт, который является лучшим в борьбе с вирусами и бактериями, паразитами, кроме того, он также способствует выведению тяжелых металлов).
Все приправы: имбирь, зира, куркума, корица, лист лавровый, кориандр, мускатный орех и др.Все кислые ягоды: смородина, крыжовник, калина, рябина, брусника, клюква, облепиха, черника, ежевика, голубика.
Живица. Живица представляет собой клейкую густую массу, которая выделяется из надрезов или трещин на коре хвойных деревьев (кедра, сосны, пихты, ели). Это вещество, вытекая, постепенно застывает и превращается в смолу. В состав живицы входят фитонциды, эфирные масла и смоляные кислоты, которые и способны противостоять грибку.
Масло кедрового ореха, кунжутное, льняное масло. Ударный подход в период противомикозных мер – это приём по 1 чайной ложке масла за полчаса до еды, 3 раза в день. А если масло принимается просто для профилактики, то можно и один раз в сутки, но в течение более длительного периода. Кроме того, для профилактики можно добавлять в салат 1 чайную ложку такого масла.Прополис. Можно пить настойку прополиса, класть прополис в мёд или просто жевать его, держать во рту.
Гвоздика (специя). Её перемалывают в порошок на кофемолке (не следует покупать уже перемолотую гвоздику) и принимают по чайной ложке с верхом 2-3 раза в день, запивая теплой водой, натощак (не менее, чем за 30 минут до еды). Курс – 2 недели.
Масло чайного дерева. Если присутствует сильное грибковое поражение, можно принимать по одной капле этого масла, растворённого в любом жире, порядка двух месяцев.
Кисломолочный напиток курунга. Кефир может быть получен как под воздействием грибка, так и с помощью ацидофильных молочно-кислых бактерий. Такой кефир является лечебным. Если, например, взять 10 таблеток курунги и положите их в литр натурального молока, то получится прекрасный продукт с противогрибковым действием, потому что молочно-кислые бактерии способны восстановить баланс микрофлоры кишечника и уменьшить популяцию грибов.
Включить щелочные процедуры. Последовательный щелочной уход за телом с общими ваннами и регулярными ножными ванночками, регулярное использование «щелочных носков» очень сильно воздействуют на все патогенные организмы в теле человека.
Также при микозах важно щелочное питье и ежедневное употребление до 1,5 литров воды.
Важно не зацикливаться на борьбе с конкретными симптомами проявления грибов, а подходить к этому вопросу целостно. А это значит прежде всего понимать, что без изменение общей среды в организме, ситуацию не изменить.
Если мы посмотрим внутрь себя, то увидим и поймём, что внутренние способности нашего организма очень велики. В наших силах способствовать укреплению тела и поддержке его в задаче сохранения здоровья. Для этого нужны наша энергия, целеустремленность, знания, нужна большая вера, правильный образ жизни, который мы будем вести каждый день.
Только зарегистрированные и авторизованные пользователи могут оставлять комментарии.
0
какой Алексей? что за сайт?
- ↓
+7
Спасибо, Марина! Очень полезная статья.
- ↓
+5
Спасибо.
- ↓

